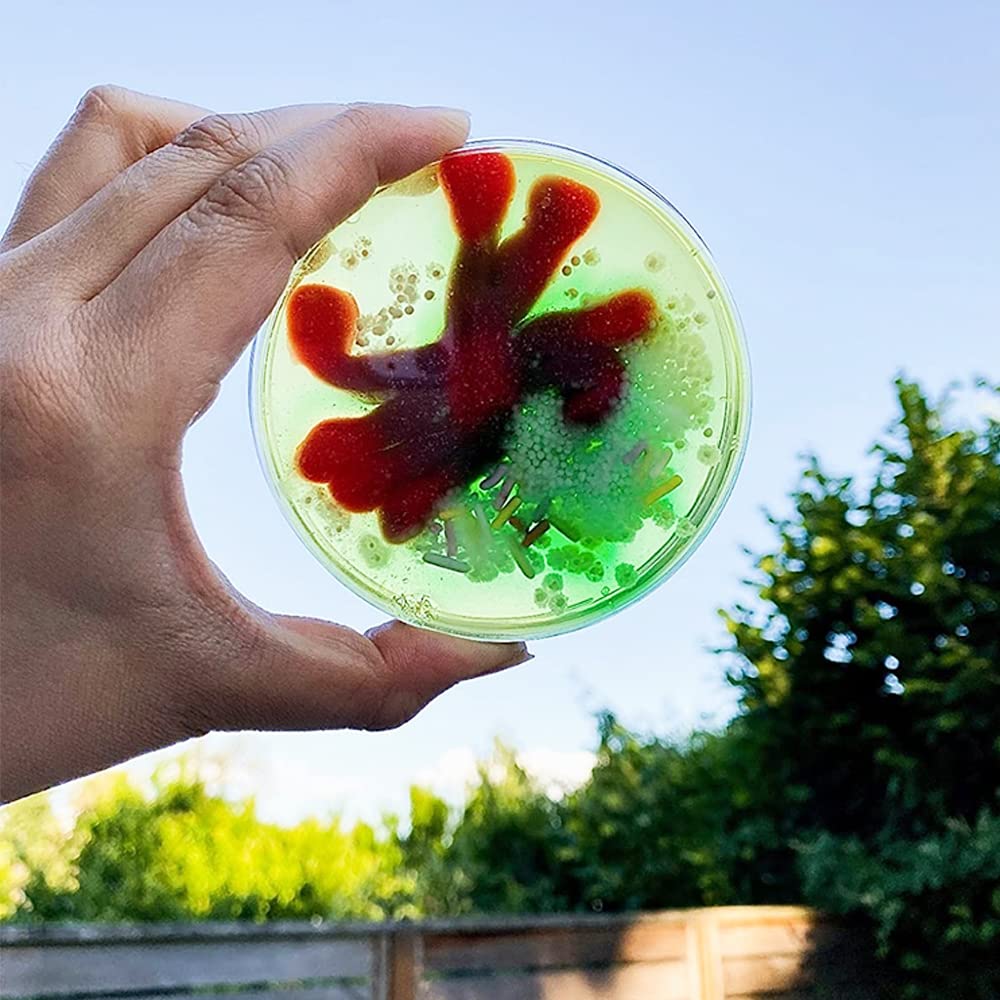
10 Piastre Petri Sterili 90mm - Plastica Trasparente Per Laboratorio E Colture

Kit Apri Ostriche Eteslot - Coltello E Morsetto In Legno Per Aprire Ostriche E Crostacei
Disponibile
Disponibile
€ 2
AGGIUNGI AL CARRELLO
Consegna
- Corriere espressoda venerdì 6 febbraioGRATIS
Venduto e spedito da ePRICE

Altri 10 venditori a partire da € 3
- Informazioni legali
- Ne hai uno da vendere?
- 1047879
- 25409479417
Pensati per Te
Prodotti simili
Descrizione
Set in legno con coltello e morsetto per aprire ostriche, vongole e crostacei senza fatica. Design ergonomico che protegge le mani. Leggero e compatto, perfetto per picnic o cucina casa. Materiali di qualità, facile da pulire. Prezzo accessorio per un prodotto professionale. Ideale per amanti dei frutti di mare. Confezione elegante, ottima come regalo. Soddisfazione garantita.Caratteristiche e scheda tecnica
Caratteristiche principali
- EAN1891327581087
Recensioni
2026-01-29 | 5w0jweb